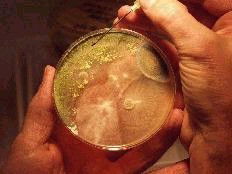
החלק החשוב ביותר בטיפול הוא מציאת אוכלוסיית פטריות עובש בבית (לרוב הן שוכנות במקומות עם לחות גבוהה) וכן וויסות אחוזי הלחות בתוך הבית. מומלץ אף לקחת דגימות אוויר על מנת לחשב את רמות הזיהום על ידי נבגי עובש בתוך מבני מגורים.

המרפאה שלנו מציעה בדיקות יחודיות לאבחון של אלרגיה לתרופות.
אבחנה של אלרגיה לתרופות מתבצעת על ידי קביעת נוגדני IgE ו IgG לתרופה.
היום יש טכנולוגיות שמאפשרות לזהות תגובה חיסוננית לא תקינה לתרופות לפי פרמטרים מעבדתיים שונים:
בדיקות מעבדה ותבחיני עור לאבחון אלרגיה.
יש לציין כי לא כל הסוגים של אלרגיות ניתן לאבחן בעזרת בדיקת דם. המטרה זו מושגת באמצעות תבחיני עור מיוחדים.
רק מומחה באלרגיה ואימונולוגיה יכול לקבוע איזה טסטים מתאימים לך כדי לזהות גורם לאלרגיות.
במרפאה אנחנו מבצעים תבחיני עור ליותר מ 160 אלרגנים שונים: אבקת דשא ועצים, קרדית אבק בית אלרגנים, עובש, פרוות בעלי חיים, מזון וכו
מחלות, בהם מתמחת המרפאה שלנו (ילדים ומבוגרים)
נזלת אלרגית, סינוסיטים, דלקת הלחמית
קדחת שחת (אלרגיות עונתיות)
אלרגיות לחיות מחמד
אלרגיות לאבקת עץ ודשא
אלרגיה לעובש ופטריות (כולל שמרים)
אלרגיות בזמן ההריון
אלרגיות אצל תינוקות
אלרגיה בהנקת תינוקות
מחלות אוטואימוניות
אסתמה ( Bronchial asthma ) שיעול ממושך וכרוני
זיהום ההרפס (הרפס חוזר, זיהום בנגיף אפשטיין בר, זיהום ציטומגלווירוס)
חוסר חיסוני (Immunodeficiencies )
חוסרים חיסוניים ראשוניים (כשלים חיסוניים מולדים)
כשל חיסוני נרכש
סרפדת (Urticaria)
אנגיואדמה (Angioedema)
אנגיואדמה תורשתית
אטופיק דרמטיטיס (אסתמה של העור)
אלרגיה ללטקס
אלרגיה לתרופות
אלרגיה למזון
אי סבילות למזון
pseudoallergy למזון
הפרעת סובלנות להיסטמין
תסמונת עייפות כרונית וכשל חיסוניים
חסרים חיסוניים חולפים
מחלות שכיחות וממושחות אצל ילדים
נזלת אלרגית היא מחלה דלקתית כרונית של בדרכי הנשימה העליונות, הקשורה לרגישות יתר המתווכת על ידי אימונוגלובולין E לאלרגנים נשימתיים.
בשנים האחרונות השכיחות של נזלת אלרגית עולה בכול העולם. בארץ כ-10-15% של האוכלוסיה סובלים מהמחלה.
המחלה מתאפיינת בסימפטומים הבאים:
התחלואה הנלווית של נזלת אלרגית:
אין עדיין טיפול שיכול לרפא את המחלה.
הטיפול בעיקר סיפטומטי, אשר משלב:
![]() | ![]() | ![]() |
מהי אלרגיה לאבקת פרחים?
מיליוני אנשים בכל העולם סובלים מאלרגיות עונתיות או מאלרגיה לאבקת פרחים. בעיה זו אקטואלית מאוד גם בארץ. בשל האקלים החם ישנה בארץ פריחה של צמחים רבים במשך רוב השנה עם תנודות מסוימות באינטנסיביות שלה. מי מאתנו לא פגש לאחרונה חבר המתלונן על תופעות כמו התעטשויות, גודש וגרד באף וכן גרד בגרון ובעיניים? אלה הם תסמיני נזלת אלרגית עונתית שמקורה באלרגיה לאבקת פרחים.
נזלת אלרגית עונתית או קדחת השחת הן למעשה תגובה של מערכת החיסון שלנו המזהה בטעות את אבקת הפרחים בתור גוף זר (כגון חיידק או נגיף) שחדר לגופינו. מערכת החיסון מתחילה לייצר נוגדנים מסוג IgE, הייחודיים לאבקה מסוימת. נוגדנים אלה "משוגרים" לריאות, לגרון, לעיניים ולעור על מנת לתקוף את האלרגן. בעת מגע חוזר עם חלקיקי האבקה, מופעל מנגנון הדלקת האלרגית הגורמת להפרשת היסטמינים וחומרים פעילים אחרים המשתחררים לתוך מחזור הדם. חומרים אלה הם הגורמים לתסמיני האלרגיה המוזכרים לעיל.
אבקת פרחים – תאי רבייה זכריים של צמחים. צמחים המאובקים באמצעות הרוח (עצים חסרי פרחים, עשבים בכלל ועשבי בר בפרט) מייצרים חלקיקי אבקה הגורמים לאלרגיה. חלקיקים אלה הינם יבשים ובעלי משקל נמוך ולכן הם נשארים הרבה זמן באוויר ומאבקים צמחים אחרים באמצעות הרוח. צמחים פורחים, לעומת זאת, תלויים בחרקים המעבירים את האבקה הכבדה והדביקה שלהם מצמח אחד למשנהו. חלקיקי אבקה של צמחים אלה, גם כשהם נמצאים באוויר, שוקעים במהרה. ובכן, צמחים פורחים אינם גורמים לאלרגיה לאבקת צמחים.
אנשים שונים רגישים לאבקה של צמחים שונים. עם זאת, ישנה סבירות גבוהה שאנשים המפתחים אלרגיה לזן אחד של צמחים, יפתחו רגישות גם לסוגי צמחים אחרים.

טבלה של פריחת צמחים יכולה לסייע לסובלים מאלרגיה לתכנן יציאות לטבע ופעילויות שונות המבוצעות באוויר הפתוח בהתאם לפריחה העונתית. טבלה זו כוללת סוגי צמחים מחולקים לקבוצות, בהתאם לאזור הגיאוגרפי שלנו (ישראל).
אסתמה היא אחת המחלות הנפוצות בעולם, ומספר החולים בה מוערך בכ-300 מיליון. כ 8-10 % מכלל האוכלוסייה המבוגרת בעולם חולה באסתמה, וכ-15% מכלל ילדי העולם סובלים ממנה. רוב חולי אסתמה הם ילדים. אסתמה פחות נפוצה במדינות המתפתחות, בעשורים לאחרונים חלה עלייה במספר החולים בכל העולם. | בתמונה באופן סכמטי מתואר מה מתרחש בתוך הסימפונות. אלרגנים גורמים לשרשרת של תהליך דלקתי בה משתתפים תאים שונים של מערכת החיסון. החומרים הדלקתיים הפעילים (כגון היסטמין ולאוקוטריאנים מופרשים מתאיי פיתום) גורמים לאודם, בצקת והפרשות בתוך רקמת הסימפונית | ראו השוואה בין הסימפונות אצל בן אדם בריא ואצל חולה עם קצרת. דלקת אלרגית בתוך הסימפונות מביא לבצקתיות ואודם בתוך הסימפונות, הפרשות מרובות (רירית וכיח) בתוך הסימפונות.כל אלו מביאים להיצרות של הקוטר של הסימפונות המודלקים. |
![]() מספר פקטורים גורמים להחמרת אסתמה או להתקף של אסתמה. | ![]() ![]() | לצורך מעקב ביתי אחרי אסתמה משתמשים במכשיר פשוט (פיקפואומטר ). החולה מקבל הדרכה אין להשתמש במכשיר פיקפלואומטר. לפי המצב של חסימת הסימפונות הוא מקבל הנחיות קליניות. |
תרופות לטיפול אסתמה. | ![]() גישה מודרנית לטיפול של אסתמה. |
סינוסיטיס היא אחת המחלות הנפוצות בכלל האוכלוסייה בכל הגילאים. אדם אחד מתוך שבעה, בקירוב, יסבול מסינוסיטיס במהלך השנה. אחוז ניכר מהפונים למרפאות לקבלת טיפול אמבולטורי בחודשי החורף הם אנשים הסובלים מדלקת גת. קיים קשר ישיר בין אסתמה וסינוסיטיס. מחקרים אפידמיולוגיים מראים שעד 75% מהחולים הסובלים ממחלת האסתמה מפתחים סינוסיטיס. יתר על כן, אצל הסובלים מאסתמה משמש הסינוסיטיס אחד הגורמים להחרפת המחלה ולהתקפים קשים יותר.
סינוסיטיס היא דלקת בגתות האף. גתות האף אלה הם חללים בעצמות הפנים בגולגולת. לכל אדם ארבעה זוגות גתות המקושרות ללוע עליון באמצעות פתחים זעירים המכוסים רירית. דרך הפתחים הללו יוצא ונכנס אוויר ונוזל רירי הנוצר בין הגתות ללוע העליון. דלקת בגת אחת או במספר גתות גורמת לבצקת ברירית, מה שמעקב את מעבר האוויר והנוזלים בין הגתות ללוע. דלקת הרירית יכולה לנבוע מזיהומים נגיפיים של דרכי הנשימה העליונות ו/או מאלרגיה. כתוצאה מכך מצטבר בגתות נוזל רירי המזדהם על ידי חיידקים שונים.
מבחינים בין שני סוגי סינוסיטיס: חריף וכרוני. ההבחנה בין שני הסוגים נעשית בעיקר על בסיס חישוב משך המחלה.
סינוסיטיס חריף עוקב הרבה פעמים לזיהום חריף בדרכי נשימה, כגון התקררות או שפעת, והוא נמשך מספר שבועות. סינוסיטיס כרוני נמשך יותר מ-8-12 שבועות, והוא עלול לגרום להיעדרות ממושכת ממקום עבודה או מלימודים. יתר על כן, סינוסיטיס כרוני עלול לפגוע פגיעה בלתי הפיכה בגתות האף.
כיצד מבחינים בין סינוסיטיס להתקררות רגילה?
לרוב דומים תסמיני הסינוסיטיס החריף בתחילת המחלה לתסמיני התקררות, לכן לא קל להבחין בשלב זה בין השניים. אם הנך סובל מגודש באף במשך יותר משבוע ומתלווים לכך כאבי ראש וכאבי פנים, אם הנך שם לב שהגודש מתחיל לקבל אופי מוגלתי, ייתכן מאוד כי הנך סובל מסינוסיטיס חריף.
אם הנך סובל באופן כרוני מתסמיני התקררות ותסמינים אלה נמשכים לעתים במשך כמה חודשים, ייתכן שזהו סינוסיטיס כרוני. תסמין נוסף של סינוסיטיס כרוני הוא הפרשה תמידים של נזלת צמיגית בצבע צהוב-ירוק – תופעה זו מצביעה על זיהום בגתות האף. תסמינים נוספים כוללים: כאבי ראש באזור המצח, כאבי פנים מסביב לעיניים ו/או באזור הלחיים , כאבים באזור החך וכאבי שיניים, שיעול כרוני. אם מופיעים אצלך באורח קבע שניים או יתר מהתסמינים שצוינו לעיל, יש צורך לגשת לברור רפואי.
מהו הטיפול בסינוסיטיס?
הטיפול בסינוסיטיס מתרכז במתן אנטיביוטיקה לצורך דיכוי הזיהום והקלה על תסמיני המחלה. כפי שכבר ציינו, חלק מחולי הסינוסיטיס סובלים אף מנזלת כרונית. זוהי הסיבה לכך שישנם רופאים המשלבים מתן סטרואידים לאף לטיפול מקומי בצורת תרסיס עם הטיפול הניתן לסינוסיטיס כרוני. בחלק מהמקרים ישנו צורך בהתערבות כירורגית על מנת לנקות את גתות האף מרקמה מוגלתית פגועה.
סינוסיטיס כרוני היא מחלה אלרגית
בעבר מקובל היה לחשוב שהסיבה לסינוסיטיס כרוני היא זיהום חיידקי בגתות האף ולהציע לחולים טיפול אנטיביוטי. אך המחקרים האחרונים שוללים את המקור הזיהומי של מחלה זו. למעשה, הטיפול האנטיביוטי אינו יעיל בחולים הסובלים מסינוסיטיס כרוני. הגורם האמיתי למחלה הן פטריות עובש – אלרגנים נפוצים. מחקרים מדעיים מראים שלכמות חלקיקי פטריות אלה הנמצאים באוויר ובחלל האף קשר ישיר לחומרת הדלקת ברירית גתות האף. יתר על כן, הרחקת חלקיקים אלה מהסביבה ומחלל האף גורמת להקלה משמעותית במהלך הסינוסיטיס הכרוני. נציין גם שדלקת אלרגית כרונית, שמקורה בפטריות עובש, גורמת להגדלת פוליפים באף ולעיבוי הרירית, מה שמקשה עוד יותר על הפרשת הליחה. פוליפים קיימים גורמים לזיהומים משניים ומזרזים את תהליך ההגדלה של פוליפים נוספים. כך נוצר מעגל קסמים הגורם לדלקת כרונית בגתות האף.
הטיפול בסינוסיטיס כרוני: שלב ראשון – פיקוח על אוכלוסיית פטריות עובש!
החלק החשוב ביותר בטיפול הוא מציאת אוכלוסיית פטריות עובש בבית (לרוב הן שוכנות במקומות עם לחות גבוהה) וכן וויסות אחוזי הלחות בתוך הבית. מומלץ אף לקחת דגימות אוויר על מנת לחשב את רמות הזיהום על ידי נבגי עובש בתוך מבני מגורים. לרוב עוסקות בכך מעבדות מיוחדות. באפשרותך להזמין בדיקה זו באמצעות המרפאה שלנו. במהלך הבדיקה ממוקמת צלוחית מיוחדת המכילה סביבה מזינה עבור פטריות העובש למשך שעה במקומות המועדים לפורענות (חדר שינה, מטבח, סלון ומקלחת). לאחר מכן שולחים את הצלוחיות למעבדה לביצוע בדיקה. אם בעת הספירה נמצאות מעל לארבע מושבות של פטריות עובש, ישנו צורך לבצע טיפול מיוחד נוגד עובש בבית. סביר להניח ששמירה על אוויר נקי בהמשך (צמיחה של < 4 מושבות של פטריות עובש בבדיקת מעבדה) תביא להקלה משמעותית במהלך סינוסיטיס ונזלת כרוניים.
לצורך שטיפת נבגים מריריות גתות האף ושמירה על מרקם תקני של הליחה מומלץ לשטוף את אף ואת הגתות במי מלח או במי ים. אנו ממליצים על שימוש במכשירי שטיפה לצורך ביצוע פרוצדורות אלה.
לסיכום
אנו מקווים שעכשיו הנך יודע יותר על סינוסיטיס כרוני. ההכרה שלנו במקומה של הדלקת האלרגית בהתפתחות המחלה חשובה בהחלט. לא פחות חשוב להבין את תפקידן המשמעותי של פטריות עובש בשימור התהליך הדלקתי. ובכן, הטיפול בסינוסיטיס כרוני חייב להיות טיפול מערכתי: יש להפחית את רמת זיהום האוויר בנגבי פטריות עובש ולשלב את מאמציהם של רופאי אף אוזן גרון ושל מומחים לאלרגיה.
![]() | ![]() | ![]() |
עד כמה נפוצה האלרגיה לחיות מחמד?
על פי נתונים אפידמיולוגיים, עד 10% מכלל האוכלוסייה סובלת מאלרגיה לכלבים או לחתולים. אלרגיה לחתולים נפוצה פי שניים מאלרגיה לכלבים. בבתים רבים בארץ מחזיקים כלב או חתול בתוך חללים סגורים. גם לאחר הרחקת בעל החיים, נשארים האלרגנים במבני המגורים לאורך זמן ארוך ועלולים לגרום לתגובה אלרגית אצל אנשים רגישים.
מה גורם לאלרגיה לבעלי חיים?
רבים חושבים שפרוות בעלי החיים היא זו שגורמת לאלרגיה. אך למעשה הגורם לאלרגיה זה לא הפרווה אלא הקשקשים (תופעה דומה לקשקשת שבבני אדם) המופרשים לסביבה כל הזמן. אלה הם אלרגנים זעירים ולא ניתנים לזיהוי בעין אנושית, הם נעים באוויר ושוקעים בתוך רהיטים, שטיחים ווילונות.
קשקשים אלה נוצרים מתאי האפידרמיס (שכבת עור עליונה). אפידרמיס של כלבים ושל חתולים מורכב משכבות תאים רבות הנעות כל הזמן כלפי מעלה על מנת להחליף את תאי העור המתים. אצל רוב הכלבים והחתולים חוזר תהליך זה על עצמו מדי שלושה שבועות. תאי האפידרמיס העליונים מתים ומופרשים לסביבה בתור קשקשים. בגזעי כלבים מסוימים (קוקר ספניאל, ספניאל, טרייר, סטר), במקרה של מחלת הסבוריאה, מחזור החילוף באפידרמיס נמשך לא יותר מ-3-4 ימים. גם כמות הקשקשים המופרשים גדלה במקרה זה. בנוסף לקשקשים, גם רוק ושתן של כלבים וחתולים גורמים בחלק מהאוכלוסייה לאלרגיה. אלרגנים אלה מצטברים בפרוות בעלי החיים בעת ליקוק והטלת שתן. כשהפרווה מתייבשת, חלקיקים מיקרוסקופיים של אלרגנים אלה מופרשים לאוויר וגורמים לתגובות אלרגיות.
האם ישנם גזעים של כלבים וחתולים שאינם גורמים לאלרגיה?
חתולים זכרים מפרישים כמות רבה יותר של אלרגנים מאשר נקבות. לאחרונה פותח גזע חתולים חדש, חתולים מגזע זה אינם מייצרים אלרגנים כלל. למרבה הצער לא ידועים גזעים של כלבים שאינם מפרישים קשקשים הגורמים לאלרגיה. יש להניח שכלבים מכל הגזעים, הסובלים מבעיות עור, יפרישו יותר אלרגנים מכלבים בריאים.
כיצד אפשר להימנע מתגובה אלרגית לבעלי חיים?
ישנם מקרים שבהם מגלה רופא אלרגולוג אצל החולה אלרגיה לחיית מחמד שהחולה מחזיק בבית. ברור שהתגובה האלרגית תימשך כל עוד יוחזק בעל החיים בתוך הבית, אך לעתים אין זו משימה פשוטה לשכנע את החולה להיפרד מחיית מחמד אהובה. במקרים אלה כל מה שנותר לרופא לעשות, זה לתת כמה עצות שימושיות: